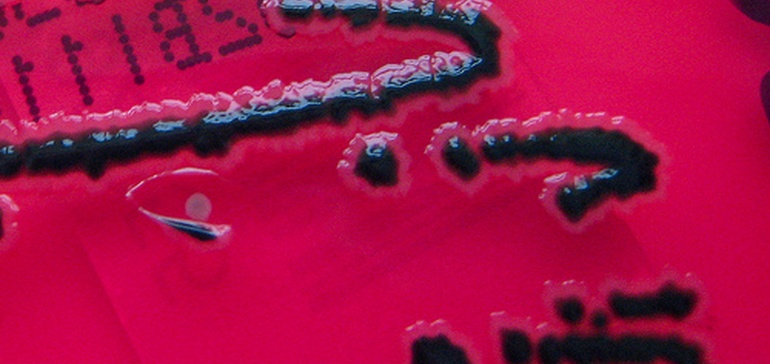

潜水简介:
- 美国花生公司前厂长塞缪尔·莱特西承认了所有与沙门氏菌爆发有关的指控,在这次爆发中,9人死亡,约700人患病。
- 早些时候曾经认罪的Lightsey达成了与检察官达成协议,这将限制在监狱中的时间最多六年。Lightsey Joins Daniel Kilgore,这是一个曾认识的花生公司的前任主管。
- 灯笼预计和Kilgore有望根据与爆发有关的其他三名高管作证。
潜入洞察力:
沙门氏菌是一个令人讨厌的事。但涉及美国花生公司的案子比平常更粗糙。典型的食物中疾病爆发涉及某种形式的错误。但在这种情况下,联邦调查局认为,高管误解了任何人的人,而是将他们所知道的产品污染,而是被摧毁。